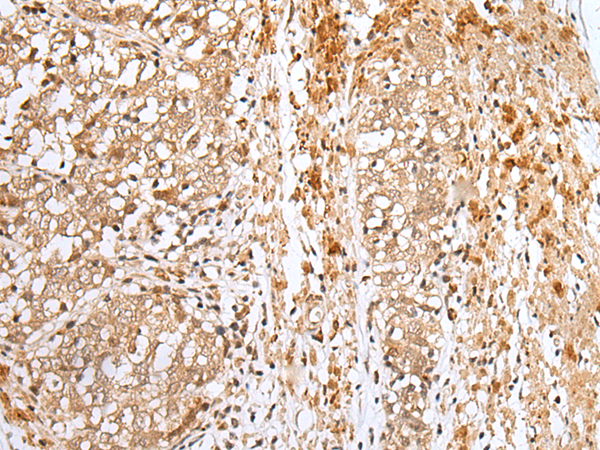

中文名稱: 兔抗NPHS1多克隆抗體
英文名稱: Anti-NPHS1 rabbit polyclonal antibody
別 名: CNF; NPHN; nephrin
相關(guān)類別: 一抗
抗 原: NPHS1
儲(chǔ) 存: 冷凍(-20℃)
宿 主: Rabbit
反應(yīng)種屬: Human
標(biāo) 記 物: Unconjugate
克隆類型: rabbit polyclonal
技術(shù)規(guī)格
|
Background: |
This gene encodes a member of the immunoglobulin family of cell adhesion molecules that functions in the glomerular filtration barrier in the kidney. The gene is primarily expressed in renal tissues, and the protein is a type-1 transmembrane protein found at the slit diaphragm of glomerular podocytes. The slit diaphragm is thought to function as an ultrafilter to exclude albumin and other plasma macromolecules in the formation of urine. Mutations in this gene result in Finnish-type congenital nephrosis 1, characterized by severe proteinuria and loss of the slit diaphragm and foot processes. |
|
Applications: |
ELISA, IHC |
|
Name of antibody: |
NPHS1 |
|
Immunogen: |
Synthetic peptide of human NPHS1 |
|
Full name: |
nephrosis 1, congenital, Finnish type (nephrin) |
|
Synonyms: |
CNF; NPHN; nephrin |
|
SwissProt: |
O60500 |
|
ELISA Recommended dilution: |
5000-10000 |
|
IHC positive control: |
Human lung cancer |
|
IHC Recommend dilution: |
25-100 |
購(gòu)物車
幫助
021-54845833/15800441009
